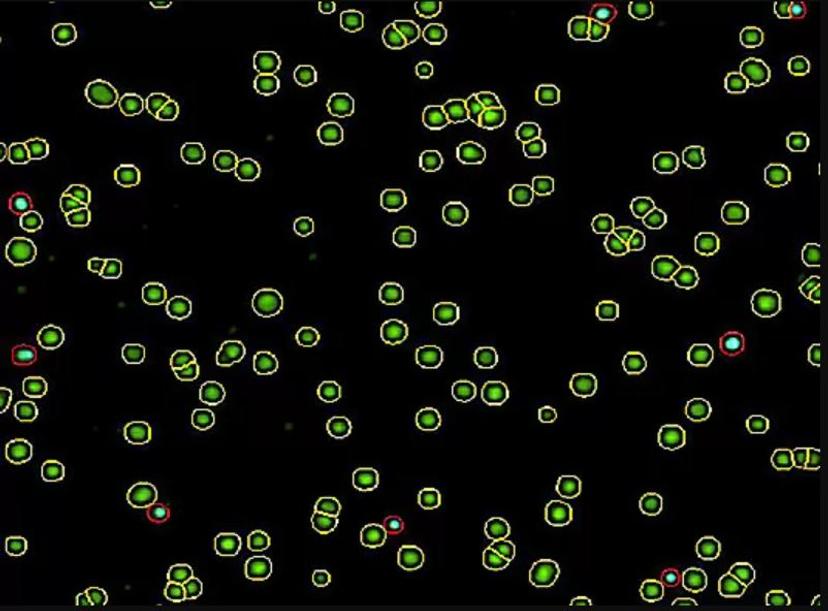

Consistent cell count & viability for development & manufacturing
ChemoMetec is determining viability and cell count precisely with its new technology
17 Aug 2022
One of the most promising approaches in cellular therapies is immunotherapies using engineered T cells or natural killer (NK) cells expressing chimeric antigen receptors (CARs). During all steps of clinical CAR-T and CAR-NK cell manufacturing, the viability and cell count must be determined precisely.
Enumeration of CAR-T and CAR-NK cells in cell therapy research and manufacturing is challenging. Manufacturing in a cleanroom environment and sometimes performing the same processing protocol for any given therapeutic products at different sites, put large demands on the cell counting method of choice, since identical cell counting is crucial.
In contrast to traditional bioprocesses that rely on the expansion of cell lines in a bioreactor, autologous cell therapies are made from individual donor tissues undergoing multistep manufacturing processes. Thus, substantial sample diversity is observed during the manufacturing of cell therapies.
Adoptive immunotherapies using engineered CAR-T & CAR-NK cells
One of the most encouraging cell therapy approaches is adoptive immunotherapy using autologous cytotoxic T cells or natural killer (NK) cells. These advanced therapy medicinal products (ATMP) are the center of attention for biopharma companies worldwide since they hold the promise of personalized medicinal approaches with better patient outcomes.
T cells can be engineered to express either T cell receptors (TCRs) or chimeric antigen receptors (CARs) to enhance their specificity and toxicity towards cancerous cells. Newcomer CAR-NK cell therapies mainly target cancers and may have a great potential in allogeneic therapies due to their immunophenotype causing very little graft-versus-host-disease1.
Creating engineered T or NK cells first involves collecting white blood cells (WBCs), or peripheral blood mononuclear cells (PBMCs), from the patient, followed by enriching the desired cell subset and genetically modifying it by viral transfection. These are then expanded to large-scale and infused back into the patient. Apart from PBMC samples, T and NK cells for CAR-modifications may come from leukopaks, bone marrow (BM), umbilical cord blood (UCB), and induced pluripotent stem cells (iPSCs).
The 224017 automated cell counter can quantify cell numbers and viability under difficult conditions often encountered in cell therapy processing, such as detecting the presence of red blood cells and sorting beads or cell clumps (aggregate cultures). The instrument demonstrates very low instrument-to-instrument variability and users experience virtually no downtime during robust manufacturing processes. With its GMP-ready software, the NucleoCounter® is ideal for cell therapy manufacturing.
NucleoCounter® automated cell counters provide a robust and accurate determination of cell count and viability of T cells during adoptive CAR-T and CAR-NK cell development and manufacturing.
Used with this cell counter, the unique Via2-Cassette™ technology combines cell sampling, staining, and counting in a single step. Pre-loaded acridine orange (AO) and DAPI dyes in the Via2-Cassette™ enable the accurate detection of T cells, even in the presence of erythrocytes, beads, or formulation reagents. As a result, the NucleoCounter® system is a reliable choice for adoptive CAR-T cell manufacturing.
Monitor the process at every step

With the NucleoCounter® NC-202™, you can continuously observe every cell counting step of the CAR-T and CAR-NK cell manufacturing process under GMP. The instrument makes it easy to monitor the purification, expansion, and formulation of CAR-T cells, all whilst ensuring precise and reliable results.
The total cell count and the dead cell count are determined by using the Via2-Cassette™. This Cell Count & Viability Assay excludes cell fragments and artifacts like micelles, as well as non-nucleated events such as platelets and erythrocytes, giving a highly accurate result. The Via2-Cassette™ is pre-loaded with AO and DAPI, preventing any problems that lead to significant inaccuracies found when using bright-field-based cell counting.
During the isolation of T and NK cells, magnetic beads may be used. These beads will not influence the cell count accuracy with the NucleoCounter® NC-202™. In conclusion, the NC-202™ can be used for every step of the cell manufacturing process.
Superior data management & presentation
The NC-View™ software enables users to conveniently view the fluorescent data image along with a more in-depth visual analysis of this data.
In the viewer, you can turn individual LED channels on and off to inspect cells—all cells are captured in the green channel, dead cells in the blue channel, and both can be seen in the merged view. You can visualize live and dead cells even more clearly, which are circled with yellow and red, respectively for easy cell verification.
NucleoCounter® NC-202™ is pre-calibrated & GMP-ready
The success of CAR-T and CAR-NK clinical trials is dependent on the development of GMP manufacturing of clinical-grade CAR-T and CAR-NK cells to safely commercialize this therapy. The NucleoCounter® NC-202™ can be effortlessly integrated into GMP and 21 CFR Part 11-compliant laboratories.
The built-in protocols for IQ/OQ/PQ ensure control of the consistent operation. Standardized PDF reports, user control, and audit trails allow for adequate documentation of usage. With the Via2-Cassette™, the variabilities normally introduced during pipetting, staining, and counting are minimized, increasing robustness in counting, and giving a highly precise result.
Want the latest science news straight to your inbox? Become a SelectScience member for free today>>
References:
W. Glienke., R. Esser., C Priesner., et al.: Advantages and applications of CAR-expressing natural killer cells. Front Pharmacol. 2015; 6: 21.